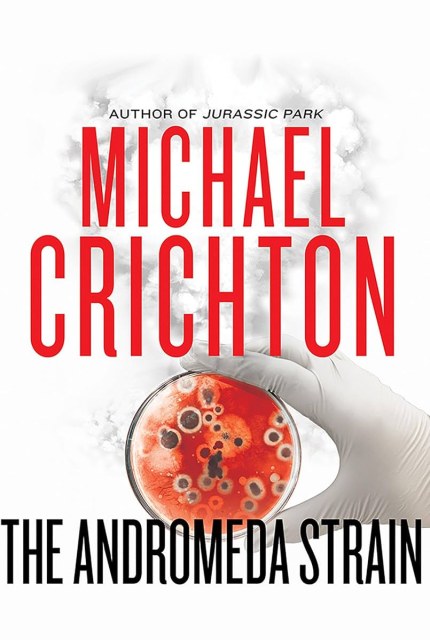
The Andromeda Strain

Books
Books read or listened by year with personal tier based rating.
S Masterpiece
A Good
B Fine
C Meh
2026
2 books
 A
A First Lord's Fury
Codex Alera, Book 6
 A
A Princeps' Fury
Codex Alera, Book 5
2025
11 books
 A
A Captain's Fury
Codex Alera, Book 4
 A
A Cursor's Fury
Codex Alera, Book 3
 B
B Academ's Fury
Codex Alera, Book 2
 B
B Furies of Calderon
Codex Alera, Book 1
 A
A Sunrise on the Reaping
A Hunger Games Novel
 A
A Isles of the Emberdark
A Cosmere Novel
 C
C The Arctic Incident
Artemis Fowl, Book 2
 B
B Dark Age
Red Rising, Book 5
 B
B Artemis Fowl
Artemis Fowl, Book 1
 B
B Percy Jackson and the Lightning Thief
Percy Jackson and the Olympians, Book 1
 B
B Iron Gold
Red Rising, Book 4
2024
11 books
 S
S Wind and Truth
The Stormlight Archive, Book 5
 A
A Morning Star
Red Rising, Book 3
 A
A Golden Son
Red Rising, Book 2
 A
A Red Rising
Red Rising, Book 1
 B
B Deadhouse Gates
Malazan Book of the Fallen, Book 2
 B
B Gardens of the Moon
Malazan Book of the Fallen, Book 1
 A
A Abhorsen
The Old Kingdom, Book 3
 B
B Lirael
The Old Kingdom, Book 2
 A
A Sabriel
The Old Kingdom, Book 1
 B
B The Lies of Locke Lamora
Gentleman Bastard, Book 1
 B
B Monster Hunter Memoirs: Fever
Monster Hunter Memoirs, Book 4
2023
9 books
 A
A Defiant
The Skyward Series, Book 4
 B
B Flashforward
 A
A The Sunlit Man
A Cosmere Novel
 B
B Wool
The Silo Saga, Book 1
 A
A Yumi and the Nightmare Painter
A Cosmere Novel
 B
B The Frugal Wizard’s Handbook for Surviving Medieval England
 S
S A Memory of Light
The Wheel of Time, Book 14
 A
A Towers of Midnight
The Wheel of Time, Book 13
 B
B Tress of the Emerald Sea
A Cosmere Novel
2022
21 books
 A
A The Gathering Storm
The Wheel of Time, Book 12
 B
B New Spring
The Wheel of Time, Prequel
 A
A The Lost Metal
Wax and Wayne, Book 4
 S
S Knife of Dreams
The Wheel of Time, Book 11
 B
B Crossroads of Twilight
The Wheel of Time, Book 10
 B
B Winter's Heart
The Wheel of Time, Book 9
 B
B Path of Daggers
The Wheel of Time, Book 8
 A
A A Crown of Swords
The Wheel of Time, Book 7
 A
A Lord of Chaos
The Wheel of Time, Book 6
 A
A The Fires of Heaven
The Wheel of Time, Book 5
 S
S The Shadow Rising
The Wheel of Time, Book 4
 A
A The Dragon Reborn
The Wheel of Time, Book 3
 B
B Dawnshard
The Stormlight Archive, Book 3.5
 S
S The Great Hunt
The Wheel of Time, Book 2
 S
S The Eye of the World
The Wheel of Time, Book 1
 A
A The Ballad of Songbirds and Snakes
A Hunger Games Novel
 B
B The Andromeda Evolution
The Andromeda Strain, Book 2
B
B The Andromeda Strain
The Andromeda Strain, Book 1
 B
B Dune Messiah
Dune, Book 2
 A
A Dune
Dune, Book 1
 B
B Evershore
Skyward Flight, Novella 3
2021
13 books
 S
S Cytonic
The Skyward Series, Book 3
 B
B The Tower of the Swallow
The Witcher, Book 4
 A
A ReDawn
Skyward Flight, Novella 2
 A
A Sunreach
Skyward Flight, Novella 1
 A
A Monster Hunter Bloodlines
Monster Hunter, Book 8
 B
B Baptism of Fire
The Witcher, Book 3
 A
A Time of Contempt
The Witcher, Book 2
 A
A Blood of Elves
The Witcher, Book 1
 B
B Sphere
 S
S Timeline
 A
A Project Hail Mary
 A
A Destroyer of Worlds
Saga of the Forgotten Warrior, Book 3
 A
A House of Assassins
Saga of the Forgotten Warrior, Book 2
2020
4 books
 A
A Rhythm of War
The Stormlight Archive, Book 4
 B
B The Rithmatist
 C
C Renegades
Expeditionary Force, Book 7
 B
B Mavericks
Expeditionary Force, Book 6
2019
32 books
 A
A The Last Wish
The Witcher, Short Story Collection
 A
A Elantris
 A
A Starsight
The Skyward Series, Book 2
 B
B Legion: The Many Lives of Stephen Leeds
 B
B Fool's Assassin
Fitz and the Fool, Book 1
 B
B Monster Hunter Guardian
Monster Hunter, Book 7
 A
A Arcanum Unbounded: The Cosmere Collection
 A
A Skyward
The Skyward Series, Book 1
 A
A Warbreaker
 A
A The Bands of Mourning
Wax and Wayne, Book 3
 A
A Heir of Novron
Riyria Revelations, Book 3
 A
A Shadows of Self
Wax and Wayne, Book 2
 B
B Rise of Empire
Riyria Revelations, Book 2
 B
B Theft of Swords
Riyria Revelations, Book 1
 A
A The Alloy of Law
Wax and Wayne, Book 1
 B
B The Disappearance of Winter's Daughter
The Riyria Chronicles, Book 4
 A
A The Death of Dulgath
The Riyria Chronicles, Book 3
 A
A Calamity
The Reckoners, Book 3
 A
A Mistborn: Secret History
Mistborn, Book 3.5
 A
A The Rose and the Thorn
The Riyria Chronicles, Book 2
 B
B The Crown Tower
The Riyria Chronicles, Book 1
 A
A Firefight
The Reckoners, Book 2
 B
B Fool’s Fate
Tawny Man Trilogy, Book 3
 A
A Steelheart
The Reckoners, Book 1
 A
A The Hero of Ages
Mistborn, Book 3
 B
B The Golden Fool
Tawny Man Trilogy, Book 2
 B
B Fool’s Errand
Tawny Man Trilogy, Book 1
 A
A The Well of Ascension
Mistborn, Book 2
 B
B Assassin's Quest
The Farseer Trilogy, Book 3
 A
A Royal Assassin
The Farseer Trilogy, Book 2
 A
A Assassin’s Apprentice
The Farseer Trilogy, Book 1
 A
A The Final Empire
Mistborn, Book 1
2018
13 books
 A
A Monster Hunter Siege
Monster Hunter, Book 6
 A
A Monster Hunter Nemesis
Monster Hunter, Book 5
 B
B Edgedancer
The Stormlight Archive, Book 2.5
 B
B Monster Hunter Memoirs: Saints
Monster Hunter Memoirs, Book 3
 A
A Oathbringer
The Stormlight Archive, Book 3
 S
S Words of Radiance
The Stormlight Archive, Book 2
 C
C Free the Darkness
King's Dark Tidings, Book 1
 B
B Into the Wild
The Malcontents, Book 2
 B
B Into the Storm
The Malcontents, Book 1
 B
B Son of the Black Sword
Saga of the Forgotten Warrior, Book 1
 S
S The Way of Kings
The Stormlight Archive, Book 1
 B
B Zero Hour
Expeditionary Force, Book 5
 B
B Monster Hunter Memoirs: Sinners
Monster Hunter Memoirs, Book 2
2017
14 books
 B
B Monster Hunter Memoirs: Grunge
Monster Hunter Memoirs, Book 1
 A
A The Martian
 A
A Monster Hunter Legion
Monster Hunter, Book 4
 A
A Monster Hunter Alpha
Monster Hunter, Book 3
 B
B Black Ops
Expeditionary Force, Book 4
 B
B Trouble on Paradise
Expeditionary Force, Book 3.5
 A
A Monster Hunter Vendetta
Monster Hunter, Book 2
 A
A Monster Hunter International
Monster Hunter, Book 1
 A
A Warbound
Grimnoir Chronicles, Book 3
 S
S Spellbound
Grimnoir Chronicles, Book 2
 A
A Paradise
Expeditionary Force, Book 3
 A
A Hard Magic
Grimnoir Chronicles, Book 1
 A
A SpecOps
Expeditionary Force, Book 2
 A
A Columbus Day
Expeditionary Force, Book 1
2016
4 books
 B
B Grave Peril
The Dresden Files, Book 3
 B
B Fool Moon
The Dresden Files, Book 2
 A
A Storm Front
The Dresden Files, Book 1
 A
A The Running Man
2015 or older
30 books
 A
A The Langoliers
 S
S The Stand
 A
A World War Z
 A
A Ender's Game
The Ender Saga, Book 1
 B
B Mockingjay
The Hunger Games, Book 3
 A
A Catching Fire
The Hunger Games, Book 2
 A
A The Hunger Games
The Hunger Games, Book 1
 B
B The Wind Through the Keyhole
A Dark Tower Novel
 A
A The Dark Tower
The Dark Tower, Book 7
 B
B Song of Susannah
The Dark Tower, Book 6
 B
B Wolves of the Calla
The Dark Tower, Book 5
 A
A Wizard and Glass
The Dark Tower, Book 4
 S
S The Waste Lands
The Dark Tower, Book 3
 A
A The Drawing of the Three
The Dark Tower, Book 2
 B
B The Gunslinger
The Dark Tower, Book 1
 A
A The Hobbit
 A
A The Hitchhiker's Guide to the Galaxy
 A
A The Return of the King
The Lord of the Rings, Book 3
 A
A The Two Towers
The Lord of the Rings, Book 2
 A
A The Fellowship of the Ring
The Lord of the Rings, Book 1
 B
B Animal Farm
 S
S Harry Potter and the Deathly Hallows
Harry Potter, Book 7
 A
A Harry Potter and the Half-Blood Prince
Harry Potter, Book 6
 S
S Harry Potter and the Order of the Phoenix
Harry Potter, Book 5
 A
A Harry Potter and the Goblet of Fire
Harry Potter, Book 4
 A
A Harry Potter and the Prisoner of Azkaban
Harry Potter, Book 3
 A
A Harry Potter and the Chamber of Secrets
Harry Potter, Book 2
 A
A Harry Potter and the Philosopher's Stone
Harry Potter, Book 1
 A
A The Lost World
Jurassic Park, Book 2
 S
S Jurassic Park
Jurassic Park, Book 1